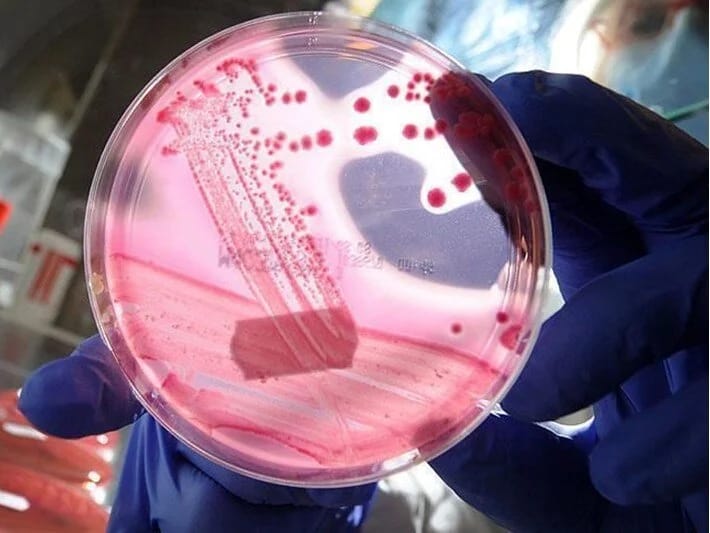
Prostat xərçəngində yeni diaqnoz tüpürcək vasitəsilə aşkar edilir

7NEWS.az xəbər verir ki, İngiltərədə aparılan bir araşdırma, tüpürcək testinin prostat xərçəngi üçün qan testindən daha yaxşı ola biləcəyini göstərdi. Ümumilikdə 6300 xəstə üzərində sınaqdan keçirilən yeni üsul sayəsində bəzi xəstələrin həyatı xilas edilib.